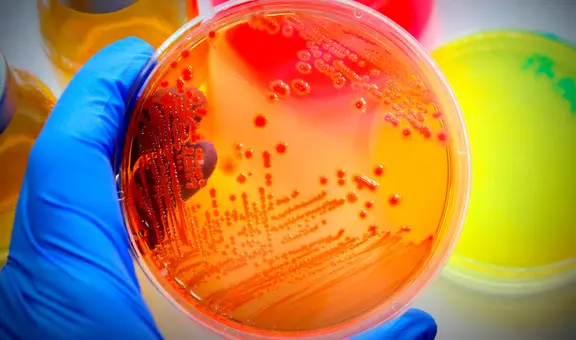
Alerta sanitaria en Florida: la bacteria que podría entrar a tu cuerpo, si no hierves el agua, según autoridades municipales

Cancelan vuelo a mujer de la tercera edad en Puerto Rico por llevar un loro: el caso reabre debate sobre derechos de los pasajeros
Una mujer de 76 años se encuentra varada en Puerto Rico después de que una aerolínea le cancelara el vuelo de regreso a Florida por viajar con su loro. Este incidente pone en evidencia las inconsistencias en las políticas de transporte de mascotas.
- Impactante caso en Florida: Mujer acusada de comprar y vender huesos humanos en Facebook Marketplace
- Licencia de conducir en Florida: FLHSMV advierte que a partir de esta edad los conductores deberán cumplir nuevos requisitos

El derecho de los pasajeros a viajar con sus mascotas sigue siendo una cuestión polémica, especialmente cuando surgen inconvenientes inesperados en medio de un vuelo. Este es el caso de María Fraterrigo, una mujer de 76 años, que quedó atrapada en Puerto Rico después de que su vuelo de retorno a Florida, Estados Unidos fuera cancelado debido a que viajaba con su mascota, un loro de cabeza amarilla. La historia ha capturado la atención de miles de personas, quienes cuestionan las políticas restrictivas de las aerolíneas y los derechos de los pasajeros en situaciones como esta.
La situación ocurrió con la aerolínea Frontier Airlines, que permitió a la mujer abordar su vuelo desde Florida hacia Puerto Rico sin problema alguno, acompañada de su mascota. Sin embargo, al intentar regresar, el personal de la aerolínea le informó que no se le permitiría viajar con su loro, alegando que el hecho de haberlo permitido en el vuelo anterior fue un error.
La importancia de las políticas en Frontier Airlines
El transporte de mascotas en vuelos comerciales es un tema que genera tanto entusiasmo como controversia. Muchas aerolíneas permiten que los animales pequeños viajen en cabina, pero otras imponen restricciones severas, lo que genera frustración entre los pasajeros. En este caso particular, la aerolínea alegó que los loros están prohibidos como mascotas en cabina, lo cual es un claro ejemplo de las diferencias que existen entre las políticas de las distintas aerolíneas.
Si bien la normativa de Frontier Airlines especifica que los loros no pueden viajar en cabina, no hay una uniformidad de criterios en la industria aérea. En algunos vuelos, las restricciones varían dependiendo del tipo de animal, el tamaño y la ubicación en la que viajan. Este incidente resalta la necesidad de que las aerolíneas tengan reglas claras, consistentes y bien comunicadas, para evitar malentendidos y garantizar el bienestar tanto de los pasajeros como de sus mascotas.
El caso y su impacto en los derechos de los pasajeros
El incidente con la mujer y su loro ha reabierto el debate sobre los derechos de los pasajeros, particularmente los de la tercera edad. Las aerolíneas tienen la responsabilidad de garantizar la comodidad y la seguridad de todos los viajeros, independientemente de su edad o necesidades especiales. Sin embargo, muchos pasajeros sienten que las políticas son aplicadas de manera inconsistente, y que no se tiene en cuenta la situación individual de cada viajero.
Las personas de la tercera edad, por ejemplo, a menudo enfrentan obstáculos adicionales cuando viajan. Además de las dificultades físicas, el estrés que ocasionan estos incidentes puede tener un impacto negativo en su bienestar emocional y psicológico. En este sentido, las aerolíneas deben ser más flexibles y considerar las necesidades específicas de los pasajeros mayores, sobre todo cuando viajan con una mascota que se convierte en parte fundamental de su vida cotidiana.
Las lecciones de este incidente para los viajeros
Para evitar situaciones similares, los viajeros deben informarse previamente sobre las políticas de las aerolíneas antes de abordar un vuelo con su mascota. Las aerolíneas tienen la obligación de comunicar de manera clara y efectiva las reglas relacionadas con el transporte de animales. Sin embargo, también recae sobre los pasajeros el asegurarse de que todos los documentos y requisitos estén en orden para evitar sorpresas a la hora de abordar.
Además, las aerolíneas deben ser más proactivas en su trato con los pasajeros que viajan con animales. En lugar de aplicar reglas rígidas que no consideran las circunstancias, deberían mostrar flexibilidad, especialmente en casos excepcionales como el de esta mujer, para evitar que el derecho de los pasajeros a viajar con sus mascotas se vea comprometido.